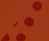

![]()








and the winners are....























































































































































































































































































































































Visiting a restaurant is a popular way to enjoy a night out with family or friends. Dining out affords individuals a break from cooking at home and offers an opportunity to try new cuisines and enjoy a complicated dish that novices may find difficult to prepare.
Special occasions also may be celebrated by dining out, bringing together a large party of customers at one time. When dining out as a crowd, some additional planning may be necessary to ensure the experience goes well.
The first thing is to consider speaking with the restaurant about how they handle large dining parties. While some restaurants may simply request a reservation (and updates on whether the party count changes), others may treat a crowd of eight or more differently and refer such groups to a party planner or catering manager. Follow the rules of the restaurant to make things easy for their kitchen staff and the waitstaff.
When bringing a large dining party, sometimes it can be easier to work with the restaurant and have a party menu set up. This menu will feature a few different options rather than giving the group free rein over the standard menu. A party menu means you can keep things to a set price and advise those dining out about
what they can expect to pay if the bill will be split.
Who will pay for the meal also merits consideration. It’s essential to decide in advance if the bill will be paid by one individual or if it will be split equally among those attending the dinner. If it is the latter, it may be easiest if everyone brings cash to make chipping in for a single check more seamless than handing over 10 different credit cards or requesting multiple checks. Also, paying cash means diners will not be subjected to the extra fee that many restaurants are now placing on credit card payments to help offset their costs for accepting such forms of payment. Plan for the group to arrive at the same time. Many restaurants will not seat a party until all diners are present. Also, once the group is finished dining, it may be tempting to linger for a while and engage in conversation. This can affect the turnover rate of the table and some establishments may not be fond of it. Rather, think about moving over to the bar area (if there is one) or take the group to another bar nearby to continue catching up.
Dining out as a large party involves planning ahead and being cognizant of the protocols in place at the establishment you will be visiting.

small businesses, while 29% prefer national retailers. Though price remains top-of-mind for many shoppers (62%), speed is a major factor, too: 53% say they want to get an item as fast as possible, no matter where it comes from, according to a new study by Empower, a financial services company.
Shoppers appreciate the personalized customer service (36%), high-quality and craftsmanship (34%) and locally made products (56%) found at the stores in their neighborhood. Lower prices (85%), greater product variety (71%) and more flexible return policies/warranties (64%) motivate consumers to pick big-box retailers. Key takeaways
* 53% want to get items as fast as possible, no matter where they come from.
* 3 in 5 (61%) prefer to buy gifts from small businesses because they can find more unique and personal options.
* Eating at local restaurants (75%) and shopping for produce at local farmers’ markets (51%) are ways consumers support their local economies.
* Monthly spending at local small businesses averages $106, with Gen X ($113) and Millennials ($110) splurging more. Purchasing preferences
Beyond price, 6 in 10 Americans prefer to purchase gifts for others at local shops because they can find more personal and unique options. Three-quarters support small businesses in their town by eating at local restau-

rants (non-chains) and shopping for produce at farmers’ markets (51%). Other local finds consumers are on the hunt for include books and media (51%) and home goods or decor (44%).
Baby Boomers (41%) and Gen X (31%) are more likely to prefer shopping locally, while Millennials and Gen Z are more flexible - 42% and 46%, respectively, say they have no preference. Gen Xers spend the most per monthly average across both local and big chain stores, followed by Millennials, while Gen Z and Baby Boomers report lower spending overall.
Average monthly spending at local small businesses, by generation:
* Gen X: $113
* Millennials: $110
* Gen Z: $96





* Baby Boomers: $88
Average monthly spending at big chain stores, by generation:
* Gen X: $379
* Millennials: $338
* Gen Z: $298
* Baby Boomers: $259
The appeal of small businesses
More than a third (35%) are willing to pay extra at a local store for a product they could also buy at a big chain. On average, consumers are comfortable paying up to $14 more, with 10% ready to spend over $30.
Convenience is another important factor, especially for younger generations. Over half of Gen Zers (56%) would shop “small” more often if faster shipping options were available.
Online platforms like Etsy have also gained traction.
About half of Americans (51%), including 54% of both Gen Z and Millennials, use these channels to support small businesses.
Additional reasons shoppers value small businesses include locally handcrafted products (56%), building relationships with owners (39%), and personalized service (36%).
Methodology
Empower commissioned an online survey of 1,009 Americans in October 2024.



















































































































































































Thank you for voting Riverside Healthcare the Best Large-Sized Business and one of the best places to work!
We are honored to serve our community with compassionate care and a commitment to excellence.
Your trust and support inspire us to continue to make a positive impact in the lives of those we serve.
Join our award-winning team with various roles available across all Riverside locations.
Find the right fit by scanning here!






















































































































Berkot’s is your local family-owned and operated grocery store. We pride ourselves on providing fresh, top-quality products while maintaining the excellent customer service you know and love.



Our new state-of-the-art packaging preserves shelf-life, reduces food waste, and increases sustainability. This allows us to offer more varieties and sizes, and to pass the savings along to you.



Our meat is cut fresh everyday by our experienced, award-winning butchersthat’s the Berkot’s difference. We are proud to be your top choice in the Southland!

Serving our communities since 1981
Fresh. Friendly. Focused on you.

We are truly honored to once again be voted #1 in Dental. This recognition reflects the trust and support of our amazing patients, and we are grateful for each of you. Thank you for allowing us the privilege to serve you, and we look forward to continuing to provide the highest quality of care.
Dr. John Vallone and staff

